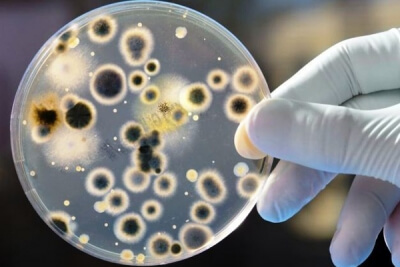
Malassezia pachydertmatis

Mit tegyek, ha vakarózik a kutyám?
„Eddig semmi baja sem volt, néhány napja viszont elkezdte vakarni, nyalni a farka tövét – mára már teljesen kiszedte a szőrét, és állatorvoshoz kellett vinnem
a gennyező seb miatt!”

„Eddig semmi baja sem volt, néhány napja viszont elkezdte vakarni, nyalni a farka tövét – mára már teljesen kiszedte a szőrét, és állatorvoshoz kellett vinnem
a gennyező seb miatt!”

Ezeket a vevői igényeket elégíti most ki az AlphaVet a széles spektrumot lefedő BiogenicVet takarmány-kiegészítő termékcsalád bevezetésével, amely több mint 30 különböző terméket tartalmaz.

A Hazai nagylétszámú broiler pulyka és sertéstelepen kipróbálva a Bronchimaxot, az alábbi eredményeket kaptuk.

Az AlphaDerm Plus Spray-t már számos uniós tagállamban törzskönyvezte az Alpha-Vet Kft. A használat során a külföldi kollégák több olyan kérdést tettek föl számunkra, amelyek a magyarországi állatorvosok számára is érdekesek lehetnek. Az alábbi kérdéseket az Ausztriában praktizáló osztrák kisállat–specialistáktól kaptuk…

A primer pyodermára példa kutyák juvenilis pyodermája. A folliculusok illetve a faggyúmirigyek fertőződnek meg – ez jellemzően a fiatal, fél-egy éves kor közötti kutyák betegsége. A fertőzött területen először apró vesiculák jelennek meg jellemzően a hasi területen, és a pofatájékon, amelyekből később gennyes hólyagocskák, impetigók alakulnak ki. Ezek könnyen felrepednek, pörkösödnek. A folyamat körkörösen terjed. A fertőzés hátterében leggyakrabban a Staphylococcus pseudointermedius áll…

A kutyák fertőzéses dermatitise (pyoderma) az esetek 95 százalékában valamilyen egyéb okból létrejövő bőrgyulladás talaján, másodlagos fertőzésként alakul ki. Kialakításában fakultatív pathogén Gram+, Gram- baktériumok és gombák játszanak szerepet, amelyek a környezetben széles körben elterjedtek és az egészséges állatok testfelszínén is jelen vannak. Többnyire ugyanezeket a mikrobákat lehet kimutatni a kutyák otitisexternájából is....

A szívférgesség évről-évre jobban terjed hazánkban, és a megjelent közlemények között ellenmondások is találhatók. Egy 2016-os akadémiai beszámoló szerint a NÉBIH-be 2001-2015 között boncolásra beküldött 2622 kutyahullában 4,6% gyakoriságot találtak, mások ugyanakkor ennél jóval nagyobb fertőzöttségről beszélnek. A parazitológia tanszékvezetőkén és a doktori iskola irányítójaként számos kutatásban vettél és veszel részt ezen a területen is – pl. Dr. Fok Évával, dr. Vörös Károllyal– mi az eltérésnek az oka?

Szaktanácsadóként gyakran beszélek állattartókkal, ahol a háztáji állományoknál a kis kiszerelések mellett gyakran felmerülő kérdés, hogy mennyi idő múlva fogyasztható a tyúkok tojása? Ráadásul ez gyakran csak akkor jut a háztáji gazdálkodó eszébe, amikor már megitatta a Neo-Te-Solt, és elmúlt a tyúkok hasmenése. Néhány napja pl. azzal hívott egy gazda, hogy van 30 tojója, akiket lekezelt – most pedig olvassa a használati utasításban, hogy a készítmény árutojónak nem adható… Akkor ő ezek után egyetlen tojását sem eheti meg ezeknek a tyúkoknak? Jó hír, hogy a készítmény törzskönyvét 2016. augusztus 8-án módosította a hatóság: tojásra az élelmezés-egészségügyi várakozási időt 0 napban határozta meg, tehát a tyúkok tojása még a kezelés időtartama alatt is fogyasztható, humán fogyasztásra értékesíthető...

A sertések reprodukciós zavarokkal és légzőszervi tünetekkel járó betegségét (Porcine Reproductive & Respiratory Syndrome, PRRS) 1987 óta ismerjük. Akkor az USA-ban diagnosztizálták, de a rá következő években több európai országban, így hazánkban is megjelent, majd pár év múlva távol-keleti országokban. A vírus törzsfejlődését vizsgáló tudósok álláspontja szerint a kórokozó eredetileg erdei rágcsálók betegségét okozta, majd róluk adaptálódott vaddisznókra végül a házi sertésre. Sőt lófélékre is, amely a lótenyésztők körében ismert és a tenyészállatok termékenyítésből való kizárását is maga után vonó fertőző arteritis (érfalgyulladás) nevű betegséget....

A krónikus, fájdalommal járó mozgásszervi betegségek kezelésében központi szerepet játszanak a non-szteroid és szteroid gyulladáscsökkentők, de a hatékony fájdalom,– és gyulladáscsökkentő hatás mellett számolnunk kell a gyomor-bél nyálkahártyára kifejtett káros hatással is. A Biogenic Pet Vitality különleges termék a palettán: a kezelés bizonyítottan javítja a mozgásszervi tüneteket, de közben csökkenti (!) az egyidejűleg alkalmazott gyulladáscsökkentő kezelés ulcerogén hatását is. A Biogenic Pet Vitality gyomorvédő hatását kísérletes modellben bizonyították: hatóanyaga gátolta az aszpirin (acetilszalicilsav) által okozott sejthalált, és jelentősen növelte az osztódó sejtek számát bélhám szövettenyészetben....

A mindennapi állatorvosi és orvosi klinikai gyakorlatban a fájdalom a leggyakoribb panasz, amely mozgásszervi betegségre utalhat és ami miatt a beteg állatokkal orvoshoz fordulnak. Lefolyása, időtartama szerint a fájdalom lehet heveny vagy idült, perzisztáló vagy intermittáló. Krónikus a fájdalom, ha annak fennállása több mint három hónap. A heveny fájdalom sokszor spontán, maradványtünet nélkül megszűnik, míg a krónikus fájdalom a centrális és a perifériás idegrendszer túlérzékenységéhez és gyakran depresszió kialakulásához vezet (2, 4). A degeneratív, idült fájdalommal járó ízületi kórképek napjainkban egyre inkább a figyelem előterébe kerülnek. E nagy betegségcsoport esetében az életminőség súlyos romlása következik be, hosszan....

A szabadban tartott kutyák és macskák téli bundát növesztenek, és megnövekszik a táplálékfelvételük a hőszigetelést szolgá- ló bőralatti zsírszövet megvastagodásának érdekében. A jó minőségű táplálás mellett ehhez szükség van a kiegyensúlyozott mikroelem pótlásra is, amelyet a Minera cseppekkel egyszerűen meg tudunk oldani: egy csepp/ttkg. A Minera cseppek látványosan javítják az állat általános kondícióját....

Elérkezett a tavaszi parazitaellenes kezelések ideje – az Alpha-Vet Kft. az állatok és a gazdák egyedi igényeinek megfelelően mindenre biztosít megoldást! – Animec Super injekció: ivermektin + klorszulon kombináció szarvasmarháknak, széles spektrumú készítmény az endo- és ektoparazitákkal szemben – a májmételyekkel szemben is hatékony! – Levafas Diamond belsőleges szuszpenzió: oxiklozanid + levamizol kombináció, ideális választás szarvasmarhák és juhok számára a májmétely fertőzéssel szemben amennyiben az orális kezelést választjuk....
A kutyák pyodermájának kórokozói között gombák is előfordulnak, önállóan vagy baktériumokkal közösen, kevert fertőzésekben. A gombák közül messze leggyakrabban a Malassezia pachydertmatis tenyészik ki a pyodermás esetekből. A Malassezia pachydermatis az élesztőgombák közé tartozik, a kutya (és az ember) normál bőrflórájának része, de kimutatható a vastagbélben és a végbélben is. Növekedéséhez lipidekre van szüksége, amely a bőr felszínén rendelkezésre áll.

A kutyákkal foglalkozó állatorvos gyakran találkozik a bőr és a szőrzet különböző eredetű megbetegedéseivel – pl. szőrhullással, bőrgyulladással. Dr. Elizabeth Lund (epidemiológus – biostatisztikus, az amerikai Banfield állatkórház-hálózat szakértője) 1,3 millió beteg adatait elemezte. Statisztikája alapján a szőr és bőrelváltozások prevalenciája a legmagasabb valamennyi kórkép közül: a rendelőbe behozott kutyák 20 százalékban diagnosztizálták.

A kutyát herélésre hozták be hozzám, de a műtét után a gazdik nem figyeltek a sebvédelemre és levették a gallért. A kutya így elkezdte nyalogatni sebét és egy felületes pyoderma alakult ki a műtéti seb környékén. Az AlphaDerm Plus spray és a Biogenic Pet együttes használatát javasoltam, néhány napos gyulladáscsökkentő kezelés mellett. A képek magukért beszélnek.

Az Egyesült Államokban a Banfield kisállat kórházlánc adatai szerint 2007-ben a vizsgálatra behozott 1,35 millió kutya 36 százalékában jelentkezett különböző hátterű szőrhullás

A tavaszi virágzási ciklusnak ugyan már vége, azonban legtöbb gondot okozó parlagfű szezon még javarészt előttünk áll.

Mi történt a kutyámmal?! "Eddig semmi baja sem volt, néhány napja viszont elkezdte vakarni, nyalni a farka tövét - mára már teljesen kiszedte a szőrét, és állatorvoshoz kellett vinnem a gennyező seb miatt!"
Sütik? Valószínűleg már hallottál róluk. Ezek apró szöveges fájlok, amelyek a weboldalra történő belépéskor elmentik a beállításaidat és preferenciáidat. Azért használjuk őket, hogy javítsuk a felhasználói élményt és személyre szabott tartalmakat nyújtsunk. Egyes sütik elengedhetetlenek, mivel biztosítják az oldal alapvető működését. Minden szakaszban eldöntheted, hogy mely sütik engedélyezését szeretnéd.
Az Alphaportal oldalon használt sütik az alábbiakban nyújtanak segítséget:
Az adatvédelemről, adatkezelésről bővebben az Adatkezelési Tájékoztatóban olvashatsz.
Funkció: Ez a beállítás lehetővé teszi a webhely számára, hogy olyan adatokat tároljon, amelyek a hirdetések megjelenítéséhez és optimalizálásához szükségesek, például cookie-kat vagy eszközazonosítókat. Ezek az információk segítik a hirdetési rendszereket abban, hogy a felhasználók számára releváns tartalmakat jelenítsenek meg.
Miért érdemes engedélyezni: Az engedélyezés révén a megjelenő reklámok jobban igazodnak az érdeklődési körödhöz, így elkerülheted az irreleváns, vagy ismétlődő hirdetéseket. Ez nemcsak hatékonyabbá teszi a hirdetéseket, hanem kényelmesebbé és gördülékenyebbé a böngészést is. Tiltás esetén is megjelennek a reklámok (például a közösségi oldalakon), csak azok nem igazodnak az érdeklődési körödhöz.
Funkció: Ez a beállítás lehetővé teszi a webhely számára, hogy gyűjtse és tárolja az olyan analitikai adatokat, mint például a látogatások időtartama, a gyakran látogatott oldalak vagy a felhasználók által végzett interakciók. Ezek az adatok segítik a webhely üzemeltetőit abban, hogy átfogó képet kapjanak a látogatók viselkedéséről, az weboldal használatáról.
Miért érdemes engedélyezni: Az ilyen információk elemzése segít a weboldal üzemeltetőinek azonosítani, hogy mi működik jól és mit érdemes fejleszteni. Ennek eredményeként a tartalmak és a funkciók még inkább igazodhatnak a felhasználói igényekhez, ami gyorsabb, kényelmesebb és hatékonyabb felhasználói élményt biztosít.
Funkció: Ez a beállítás lehetővé teszi, hogy a webhely továbbítsa a Google számára azokat a hirdetésekkel kapcsolatos adatokat, amelyek konkrétan a felhasználóhoz köthetők, például felhasználói azonosítókat vagy a felhasználó által megadott információkat. Ezek az adatok kulcsfontosságúak a hirdetési kampányok hatékonyságának mérésében és a célzás javításában.
Miért érdemes engedélyezni: Az engedélyezéssel a webhely és a hirdetési rendszerek pontosabban tudják értékelni, hogy a hirdetések mennyire érik el céljukat, és ez alapján finomítani tudják azokat. Ennek eredményeként a megjelenő reklámok jobban igazodnak az érdeklődési körödhöz, így relevánsabb és hasznosabb tartalmakat kapsz, miközben elkerülheted az irreleváns hirdetéseket.
Funkció: Ez a beállítás lehetővé teszi, hogy a hirdetési rendszerek a felhasználó érdeklődési köre, online viselkedése vagy korábbi tevékenységei alapján személyre szabott hirdetéseket jelenítsenek meg.
Miért érdemes engedélyezni: A személyre szabott hirdetések sokkal relevánsabbak a felhasználók számára, hiszen olyan termékeket, szolgáltatásokat vagy tartalmakat ajánlanak, amelyek valóban érdekelhetik őket. Ez nemcsak érdekesebbé teszi a böngészési élményt, hanem segít elkerülni a zavaró, irreleváns vagy ismétlődő hirdetéseket, így gördülékenyebb és élvezetesebb online élményt biztosít.
Funkció: Ez a beállítás lehetővé teszi a webhely számára, hogy olyan alapvető adatokat tároljon, amelyek a webhely vagy alkalmazás zavartalan működéséhez szükségesek, például a nyelvi beállításokat, a kosár tartalmát vagy más, a felhasználói élményt támogató információkat.
Információ: Az engedélyezéssel a webhely képes emlékezni a preferenciáidra, például arra, hogy milyen nyelvet választottál, vagy milyen termékeket tettél a kosárba. Ez garantálja, hogy a böngészés folyamatos, kényelmes és személyre szabott legyen, anélkül hogy minden alkalommal újra be kellene állítanod ezeket az adatokat.
Funkció: Ez a beállítás lehetővé teszi a webhely számára, hogy tárolja a személyre szabással kapcsolatos adatokat, például a korábbi tevékenységek alapján készült videó- vagy tartalomajánlásokat. Ezek az információk segítenek abban, hogy a felhasználó egyedi igényeire szabott tartalmak jelenjenek meg.
Miért érdemes engedélyezni: Az engedélyezéssel a webhely képes relevánsabb, az érdeklődési körödhöz igazított tartalmakat kínálni. Ez nemcsak élvezetesebbé teszi a böngészést, hanem időt is megtakarít, hiszen nem kell keresgélned azokat az információkat vagy ajánlásokat, amelyek valóban érdekesek számodra.
Funkció: Ez a beállítás lehetővé teszi a webhely számára, hogy olyan adatokat tároljon, amelyek a biztonságos működéshez szükségesek. Ilyenek például a hitelesítési adatok, a csalásmegelőzéshez használt információk, vagy a felhasználói adatok védelmét szolgáló intézkedések.
Információ: Az engedélyezés garantálja a webhely és a felhasználói adatok biztonságát. Ezáltal elkerülhetőek a jogosulatlan hozzáférések, csökkenthetőek a csalások, és biztosítható a zavartalan és biztonságos böngészési élmény. Az ilyen típusú tárolás az adatvédelem alapvető feltétele, amely mind a felhasználók, mind a webhely működésének érdekeit szolgálja.